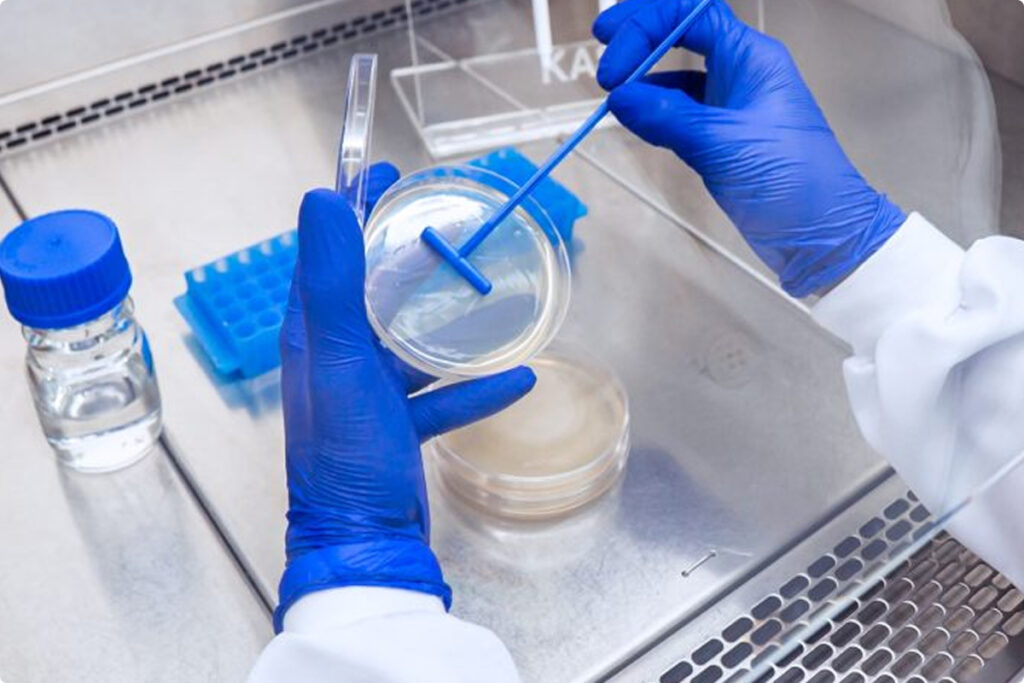

Biotecnologia como serviço
Produtos Biológicos
Desvendar modo de ação como serviço
Para empresas que precisam de argumentação técnica mais aprofundada para seus produtos comerciais.
Combinando conceitos de biologia sistêmica e tecnologias ômicas avançadas, é possível analisar profundamente o impacto do produto na fisiologia vegetal, chegando ao nível molecular.
Após validações e experimentos, é gerado um relatório detalhado com insights valiosos, capazes de impulsionar significativamente as vendas.
Além disso, frequentemente são identificados efeitos paralelos do produto, que podem ser explorados para expandir para novos mercados ou melhorar seu posicionamento estratégico.

Estudos de escalonamento
Realizamos estudos para transferência de processos do laboratório à produção industrial.
Garantimos escalabilidade, controle de processos, estabilidade do produto, purificação, gestão de resíduos e conformidade regulatória para sucesso industrial.

Descoberta do modo de ação de produtos agrícolas
Oferecemos análises avançadas para empresas que desejam entender como seus produtos agem na fisiologia da planta.
Utilizamos biologia sistêmica e tecnologias ômicas para revelar efeitos moleculares, gerando relatórios detalhados que potencializam vendas e ampliam oportunidades de mercado.

Validação agronômica
A IdeeLab realiza ensaios de validação agronômica, em ambiente controlado, com insumos agrícolas recomendados para diferentes culturas e finalidades, incluindo inoculantes, bioestimulantes e defensivos de base química e biológica.
Entregando relatórios científicos com análise de parâmetros biométricos fisiológicos, bioquímicos e moleculares.

Estudo de Compatibilidade
Realizamos estudos de compatibilidade físico-química e biológica entre microrganismos e outros insumos agrícolas, visando assegurar estabilidade, funcionalidade e segurança das formulações.
Essa análise é essencial para o desenvolvimento de produtos mistos, blends ou para o uso combinado em campo, garantindo que não haja antagonismo ou perda de desempenho microbiológico ao longo do tempo.

Controle de Qualidade
A IdeeLab dispõe de laboratórios dedicados ao controle de qualidade de inoculantes, com infraestrutura e metodologias validadas para análises microbiológicas, físico-químicas e funcionais.
Os processos de controle seguem padrões rigorosos, assegurando que cada lote produzido esteja em conformidade com os parâmetros legais e técnicos exigidos, com foco em viabilidade celular, pureza, concentração e estabilidade do microrganismo.

Consultoria em Bioprocessos, Formulação e Construção de Biofábricas
Oferecemos consultoria técnica especializada em bioprocessos industriais, desenvolvimento de formulações e implantação de unidades fabris para produtos biológicos.
Acompanhamos projetos desde a concepção até a operação, com foco em eficiência produtiva, escalabilidade, adequação regulatória e segurança operacional.
A expertise da equipe da IdeeLab permite a entrega de soluções integradas para empresas que desejam internalizar ou expandir sua capacidade de produção biotecnológica.

IdeeLab Academy
A IdeeLab promove cursos e treinamentos técnicos voltados à capacitação de equipes nas áreas de microbiologia industrial, bioprocessos, controle de qualidade, escalonamento e formulação de bioinsumos.
Os conteúdos são elaborados por profissionais especializados, com foco prático e abordagem científica atualizada.
Essas iniciativas fortalecem o ecossistema de biotecnologia, contribuindo para a formação de profissionais qualificados e preparados para os desafios do setor.
